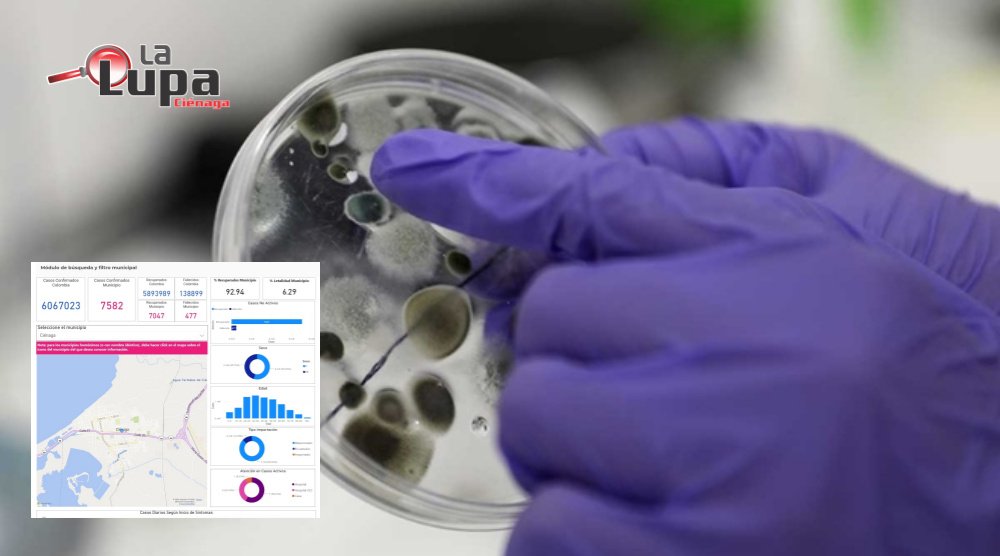

El más reciente informe del Instituto Nacional de Salud, indica que el miércoles 2 de marzo se registró un sólo caso positivo Covid 19 en Ciénaga.
La cifra de diagnósticos confirmados pasó de 7.581 a 7.582.
477, es el número de muertes reportadas en Ciénaga durante la pandemia Covid 19.
En ese orden, el Instituto Nacional de Salud informó que el número de recuperados está en 7.047 (92.94%).
58 es el número de pacientes activos, con corte a 2 de marzo de 2022.
Síguenos en la web: www.lalupacienaga.com.co